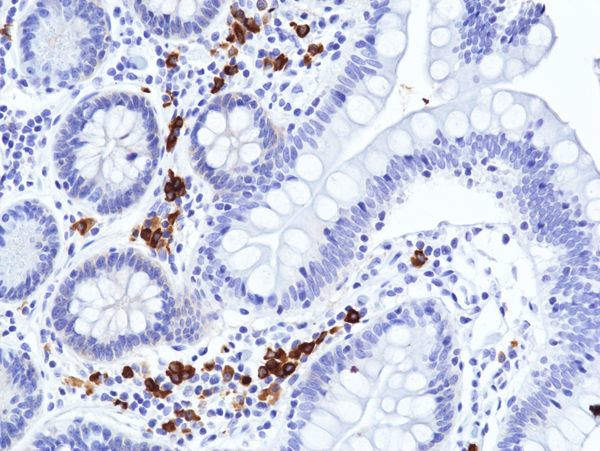

Search
Invitrogen
Human IgA (Heavy chain) Recombinant Rabbit Monoclonal Antibody (RM513)
{{$productOrderCtrl.translations['antibody.pdp.commerceCard.promotion.promotions']}}
{{$productOrderCtrl.translations['antibody.pdp.commerceCard.promotion.viewpromo']}}
{{$productOrderCtrl.translations['antibody.pdp.commerceCard.promotion.promocode']}}: {{promo.promoCode}} {{promo.promoTitle}} {{promo.promoDescription}}. {{$productOrderCtrl.translations['antibody.pdp.commerceCard.promotion.learnmore']}}
产品信息
MA562096
种属反应
宿主/亚型
Expression System
分类
类型
克隆号
抗原
偶联物
形式
浓度
纯化类型
保存液
内含物
保存条件
运输条件
RRID
产品详细信息
This antibody reacts to human IgA, including both IgA1 and IgA2. No cross reactivity with human IgG, IgM, IgD, or IgE.
靶标信息
Constant region of immunoglobulin heavy chains. Immunoglobulins, also known as antibodies, are membrane-bound or secreted glycoproteins produced by B lymphocytes. In the recognition phase of humoral immunity, the membrane-bound immunoglobulins serve as receptors which, upon binding of a specific antigen, trigger the clonal expansion and differentiation of B lymphocytes into immunoglobulins-secreting plasma cells. Secreted immunoglobulins mediate the effector phase of humoral immunity, which results in the elimination of bound antigens (PubMed:22158414, PubMed:20176268). The antigen binding site is formed by the variable domain of one heavy chain, together with that of its associated light chain. Thus, each immunoglobulin has two antigen binding sites with remarkable affinity for a particular antigen. The variable domains are assembled by a process called V-(D)-J rearrangement and can then be subjected to somatic hypermutations which, after exposure to antigen and selection, allow affinity maturation for a particular antigen (PubMed:17576170, PubMed:20176268). Ig alpha is the major immunoglobulin class in body secretions (PubMed:2241915). [UniProt]
仅用于科研。不用于诊断过程。未经明确授权不得转售。
篇参考文献 (0)
生物信息学
蛋白别名: IgA1; Immunoglobulin Heavy Constant Alpha 1; Immunoglobulin Heavy Constant Alpha 2; unnamed protein product
基因别名: IgA1
Entrez Gene ID: (Human) 3493